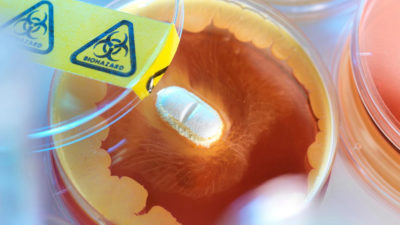
Antibiotic resistance

Antibiotic resistance

The overuse of antibiotics in humans and animals has led to the emergence of antibiotic-resistant bacteria or ‘superbugs’.
If antibiotics fail, chest infections, urinary tract infections (UTIs), cuts, insect bites and even small scratches can develop into sepsis (blood poisoning), which can be fatal. The idea of dying from a paper cut sounds impossible in this day and age, but it is again becoming a possibility (as it was in the pre-antibiotic era) – thanks to the overuse of antibiotics. The World Health Organisation says that antimicrobial resistance (AMR) is one of the main threats to modern medicine, with growing numbers of infections – such as pneumonia, tuberculosis, gonorrhoea and salmonellosis – becoming harder to treat.
AMR happens because rapid random DNA mutations occur naturally in bacteria, and these processes may help them to prosper, or have no effect. If a mutation helps a single bacterium survive antibiotic treatment, while all others die, that one will go on to reproduce, spread and take its new antibiotic-resistant gene with it, like an accessory, enabling it to survive the hostile environment – the genetic equivalent of a stab-vest!
AMR is an urgent global public health threat, killing at least 1.27 million people worldwide, which is included in the almost five million deaths associated with AMR in 2019. The number of people dying from AMR infections could rise to 10 million a year by 2050 if no action is taken to curb the overuse of antibiotics.
Soon after they were first introduced, it was discovered that when used at low doses, antibiotics could promote growth in farmed animals. This has led to their widespread use in farming around the world. It is estimated that globally, around 70 per cent of all antimicrobials sold on Earth are used in animals raised for food. The figure may be higher as many countries don’t report antimicrobial use in farmed animals. Using them to promote growth was banned in the EU in 2006, but huge quantities continue to be used in livestock for ‘disease prevention’, and in many countries, their use continues to outweigh human consumption.
In the UK, routine farm antibiotic use has been significantly reduced in recent years. However, according to the 2022 UK Veterinary Antibiotic Resistance and Sales Surveillance (VARSS) Report, 45 per cent of antibiotics used in farmed animals were added to water and 31 per cent were added to feed (23 per cent were injected). So, in the UK, over 75 per cent of farm antibiotics were used for mass medication rather than for treating individual sick animals.
The use of antibiotics in farmed animals may be rising slower than previous predictions, but it is still increasing and is expected to rise by eight per cent by 2030, driven largely by the increasing global demand for meat. This is all likely to increase the spread of AMR.
AMR is a problem of our own making; as a direct consequence of the inappropriate use of antibiotics in a drive to produce cheap meat, fish, eggs and dairy foods, on an industrial scale. The most effective way to tackle AMR, and achieve optimal health for people, animals and the planet, is to change the way we live and eat; reducing antibiotic use in humans and animals. The widespread adoption of a vegan diet would remove the factory farms that are currently the breeding grounds for these deadly superbugs.
Don’t miss the documentary Swine, produced by Viva! in 2016.
The untold story of disease and antibiotics resistance in factory farms. For decades factory farms have been abusing antibiotics. Their actions have cultivated a global environment of antibiotics resistance. SWINE exposes the global health crisis the world’s most cruel and destructive industry is trying to keep quiet.
SWINE – We are Sleepwalking into a Superbug Epidemic
Would you pay the ultimate price to save the lives of millions? Factory farming has been hiding a dark secret. For decades this unregulated and out of control industry has been abusing animals & antibiotics.
Antibiotic resistance is coming and we are running out of time…
The question is will we do so something about it?

Frequently asked questions
Antibiotics are now failing to work because they have been overused in people and farmed animals. This is a danger to all humans because antibiotic-resistant bacteria can quickly spread between people. This can result in new infectious diseases that are more difficult (potentially impossible) to treat.
Antimicrobial resistance (AMR) refers to the ability of microorganisms to withstand antimicrobial treatments. It occurs when an antibiotic can no longer control or stop bacterial growth and leads to resistant bacteria being able to live and multiply despite the presence of therapeutic levels of an antibiotic. When bacteria become resistant to most antibiotics they are referred to as ‘superbugs’.
Drug resistance is already here. The World Health Organisation warns: “For common bacterial infections, including urinary tract infections, sepsis, sexually transmitted infections, and some forms of diarrhoea, high rates of resistance against antibiotics frequently used to treat these infections have been observed worldwide, indicating that we are running out of effective antibiotics.”
Resistant infections are on the rise with over 33,000 lives lost each year to antibiotic-resistant infections in Europe and over 35,000 in the US. Worldwide, that figure rises to 1.27 million each year. If nothing is done, it is predicted that many millions will die each year – especially in poorer countries. The UN warns that 10 million people a year could die from antibiotic resistance by 2050, saying: “Antimicrobial resistance is one of the greatest threats we face as a global community”.
Leading scientists are now warning that we are in danger of entering a ‘post antibiotic’ age, which may make many routine surgical operations dangerous and could cut life expectancy. In 2012, the then-Chief Medical Officer for England, Professor Dame Sally Davies, said: “Antibiotics are losing their effectiveness at a rate that is both alarming and irreversible – similar to global warming.” And the Director of Health at the United Nations Development Programme, Mandeep Dhaliwal, warns of a return to the era before Alexander Fleming’s discovery of penicillin, saying: “We are on the road back to the days of people dying from common infections and injuries”.
Dr David Brown, director at Antibiotic Research UK, told the Guardian newspaper in 2015: “It is almost too late… The issue is people have tried to find new antibiotics but it is totally failing – there has been no new chemical class of drug to treat gram-negative infections for more than 40 years.”
Gram-negative bacteria, which include E. coli and Salmonella, have an additional, outer membrane that shields them from many types of antibiotics. This extra protection is why gram-negative bacteria are at the top of the World Health Organisation’s list of priority pathogens that need to be targeted with new antibiotics.
Although a handful of new antibiotics have been discovered (one or more of which may be effective against gram-negative bacteria), efforts to develop new ones are “insufficient to tackle the challenge of increasing emergence and spread of antimicrobial resistance” according to a review of clinical development from the World Health Organisation.
“Bacterial evolution is overwhelming our antibiotic defences” says Kim Lewis, University Distinguished Professor and the director of the Antimicrobial Discovery Center at Northeastern University, Boston, Massachusetts in the US. In other words, superbugs are developing at a faster rate than we can keep up with.
Not quite, but it could soon be. Global livestock antibiotic use is forecast to increase by eight per cent by 2030 and nearly double in Brazil, Russia, India, China and South Africa.
Dr David Brown, director at Antibiotic Research UK, told the Guardian newspaper: “I think we have got a 50-50 chance of salvaging the most important antibiotics, but we need to stop agriculture* from ruining it again.”
*Dr Brown is referring to the overuse of antibiotics in farmed animals (in the UK and around the world) ruining the chance of antibiotics working effectively.
In the UK, the Alliance to Save Our Antibiotics says around a third of antibiotics are used in animals. A lower proportion than in some countries, but still a considerable amount: 212 tonnes in 2021, according to the UK Veterinary Medicines Directorate.
Antibiotic resistance occurs when bacteria change in some way that stops the effectiveness of drugs designed to treat or prevent infections.
The overuse of antibiotics in humans and animals has led to the emergence of multidrug-resistant bacteria or ‘superbugs’. It happens because rapid random DNA mutations occur naturally in bacteria – these may help them to prosper or have no effect. If a mutation helps a single bacterium survive antibiotic treatment, while all the others die, that one will go on to reproduce, spreading and taking its new resistance gene with it like an accessory, enabling it to survive the hostile environment – the genetic equivalent of a stab-vest!
Every time we take an antibiotic we are putting pressure on bugs to find ways to resist the antibiotic. If you don’t finish a course of antibiotics, the ‘weakest’ bugs may have been killed (and you start to feel better) but unfortunately, the most resistant bugs survive and they reproduce. This is why it is so important to always finish a course of antibiotics. If you don’t take all the antibiotics, the bacteria survive and continue to multiply causing more harm. Bacteria can do this through several mechanisms. Some bacteria develop the ability to neutralise the antibiotic before it can do harm, others can rapidly pump the antibiotic out, and still others can change the antibiotic attack site so it cannot affect the function of the bacteria.
Antibiotics kill or inhibit the growth of susceptible bacteria. Sometimes one of the bacteria survives because it has the ability to neutralise or escape the effect of the antibiotic; that one bacterium can then multiply and replace all the bacteria that were killed off. Exposure to antibiotics, therefore, provides selective pressure, which makes the surviving bacteria more likely to be resistant.
In addition, bacteria that were once susceptible to an antibiotic can acquire resistance through mutation of their genetic material or by acquiring pieces of DNA that code for the resistance properties from other bacteria. The DNA that codes for resistance can be grouped in a single easily transferable package called a plasmid. This means that bacteria can become resistant to many antimicrobial agents because of the transfer of one piece of DNA.
In summary: bacteria develop sneaky ways to withstand antibiotic drugs. The more antibiotics are used in people (especially if they do not finish the course) and in farmed animals, the more likely it is that some bacteria will become resistant so that they are no longer killed by the drug. Worse still, bacteria can pass on their resistance to other species of bacteria.
Although resistance in human infections is mainly caused by human antibiotic (mis)use, for a significant number of bacteria, farmed animal use is the principal cause of resistance. The UK government says: “As in humans, the sub-optimal use of antimicrobials in agriculture and veterinary practice contributes to the rise and spread of AMR [antimicrobial resistance] all over the world”.
According to the Alliance to Save our Antibiotics, the overall weight of scientific research has led to a consensus that:
- for some bacterial infections, such as Campylobacter and Salmonella, farm antibiotic use is the principal cause of resistance in human infections.
- for other infections, like E. coli and enterococcal infections, farm antibiotic use contributes, or has contributed, significantly to the human resistance problem.
- the emergence of resistance to critically important antibiotics, in particular of ESBL [extended spectrum beta-lactamase resistance which renders bacteria resistant to modern cephalosporins] resistance in E. coli and Salmonella, is a major development that has occurred in recent years and has been driven by inappropriate use of these antibiotics in both human and veterinary medicine.
- livestock-associated strains of MRSA- [methicillin-resistant Staphylococcus aureus] infecting humans are also a developing problem, which results from the high use of certain antibiotics in farmed animals.
- some other emerging antibiotic-resistant infections in humans may be, in part, due to farm antibiotic use, but while research is ongoing, there is currently insufficient evidence to draw clear conclusions.
A main concern is that agricultural antibiotic use is driving up levels of antibiotic resistance, leading to new superbugs. Most public health experts agree that resistant bacteria are created in farmed animals by antibiotic use and that some of these are being transmitted to people and one of the major concerns to emerge in connection with such over-use is new E. coli and MRSA superbugs on farms.
Find out more here.
Antibiotic-resistant bacteria that originated in farmed animals can pass to people in several ways, mainly on foods such as meat, fish, eggs and dairy, but also by direct contact and through the environment as antibiotics are routinely released via farms’ manure and wastewater streams.
The European Food Safety Authority says that resistant Salmonella and Campylobacter involved in human disease are mostly spread through foods. For Salmonella, the most common sources are contaminated chicken, eggs, pork and beef. For Campylobacter, contaminated chicken is the main source.
Campylobacter is the most common cause of food poisoning in the UK; around half of all UK supermarket chickens carry the bacteria. Furthermore, the Food Standards Agency and Public Health England found antibiotic-resistant strains in over half the bacteria samples taken from UK supermarket chickens; 52 per cent of samples of a strain of Campylobacter isolated from chicken samples were resistant to ciprofloxacin (one of the most common antibiotics) and nine per cent of samples of another strain were resistant to at least three different kinds of antibiotic – thus qualifying it as ‘multidrug resistant’.
Most E. coli strains in the human intestine are harmless. However, cattle are a major source of verotoxigenic E. coli (eg E. coli O157:H7) and resistant strains may colonise humans via contaminated beef (or veal) more commonly than from other foods. Infection may cause diarrhoeal disease in humans ranging from mild gastroenteritis to severe bloody diarrhoea and in some can develop into a serious, potentially fatal illness.
Animal-based foods remain a potential source of methicillin-resistant Staphylococcus aureus (MRSA). Food-associated MRSA and recent reports suggest a possible increasing trend in the zoonotic transmission (from animal to human) of livestock-associated MRSA (LA-MRSA) in Europe. People who have prolonged, repeated contact with affected livestock are at a higher risk of becoming colonised with LA-MRSA but surveys conducted on retail beef, pig and poultry meat on sale in the UK have also detected LA-MRSA.
Raw meat, poultry and fish have been identified as a major source of exposure of humans to AMR bacteria, with resistance to drugs categorised by the World Health Organisation as critically important antimicrobial agents (CIAs). In a comprehensive Swiss study looking at over 100,000 food samples, raw meat, milk, seafood and certain fermented dairy products were the main offenders with a high prevalence of meat and fish harbouring Campylobacter, Enterococcus, Salmonella, E. coli, Listeria and Vibrio species of antibiotic-resistant bacteria.
The World Health Organisation recommends an overall reduction in the use of all classes of medically important antimicrobials in farmed animals and complete restriction (ie a total ban) on using medically important antimicrobials in farmed animals for growth promotion or disease prevention.
Resistant bacteria can pass from animals to people directly, via food (eg meat) or via the environment, they may also pass from people to farmed animals. Here they can multiply and acquire additional resistance genes, then pass back to humans.
According to the Alliance to save Our Antibiotics, resistant farmed-animal bacteria can contribute to higher levels of resistance in human infections in two main ways:
- they can directly cause an infection in humans, and this infection will be antibiotic-resistant
- they can colonise the human gut (and potentially other sites such as the nostrils) without causing an infection, and pass on copies of their resistance genes ‘horizontally’ to bacteria living there. The bacteria receiving the resistance genes may subsequently, cause an infection, if they get into the wrong part of the body (eg a urinary-tract infection). In this case, the pathogen will be of human origin, but its resistance will originate from the farm use of antibiotics
Worldwide it is estimated that around 70 per cent of all antibiotics are used in farmed animals. Much of this use is routine and enables animals, most often pigs and poultry but sometimes also cattle, to be kept in poor conditions where disease spreads easily. Leading authorities, such as the European Medicines Agency and the World Health Organisation, say that the overuse and misuse of antibiotics in farming are contributing to higher levels of antibiotic resistance in some human infections.
Methicillin-resistant Staphylococcus aureus (MRSA) are a group of Gram-positive bacteria resistant to numerous beta-lactam antibiotics (a broad class of antibiotics) including methicillin, amoxicillin, penicillin and oxacillin), making infection a challenge to treat.
Methicillin refers to the semi-synthetic form of penicillin that was once effective against Staphylococcus bacteria.
S. aureus is commonly found in the nose and skin of humans. About 30 per cent of the UK population are colonised with S. aureus and one to three per cent with MRSA. Both can live harmlessly on the skin (usually in the nose, armpits, groin or buttocks). Healthy individuals are usually unaware that they are carriers but may suffer from minor skin infections such as:
- boils
- pimples
- impetigo
- abscesses
- wound infections
However, S. aureus is an opportunist pathogen and if it gets further into your body, can cause more serious infections leading to:
- septicaemia (blood poisoning)
- pneumonia (lung infection)
- osteomyelitis (bone infection)
- endocarditis (heart valve infection)
- urinary tract infection (eg. bladder infection)
- septic bursitis (small fluid-filled sacs under the skin)
MRSA is a problem in hospitals because there is an increased risk that it will get into a wound and the blood will become infected. In hospitals, for example, there may be more chance the bacteria can spread from person to person via towels, sheets, razors, door handles, sinks, floors and skin-to-skin – but, of course, it also has more chance to enter the body, and invade the bloodstream through broken or damaged skin or during medical procedures, causing infections and resulting conditions that range from mild to severely life-threatening.
Antibiotic use in pig farming is one cause of MRSA, but the major cause is the human overuse of antibiotics. However, strains of MRSA are emerging from farm animals – and frighteningly quickly.
The bacterium that can cause staph skin infections can divide every half-hour in optimum conditions. Theoretically, a single cell can form a colony of more than a million cells in 10 hours.
A number of different strains of MRSA have emerged in farmed animals in recent years, which can colonise and multiply on most species, including humans.
The most common of these, livestock-associated methicillin-resistant Staphylococcus aureus sequence type 398 (LA-MRSA ST398), is an emerging zoonotic agent responsible for the massive colonisation of livestock and food products as well as infections in humans worldwide.
MRSA ST398 can colonise and cause infections in humans and a range of animals including dogs, horses and pigs. It was first detected in four pigs and one healthy pig farmer in France, then clinical infection was described in the daughter of a pig farmer in the Netherlands in 2004.
The spread of MRSA ST398 throughout Europe’s pig population in particular (it is also present in poultry and cattle), has led to a growing number of infections in humans. This strain accounted for approximately 42 per cent of human cases of MRSA in the Netherlands in 2008 and 2009, but following large reductions in farm antibiotic use, the proportion fell to 29 per cent by 2014.
Although farmers and those in direct contact with livestock are most at risk, MRSA ST398 can also pass from person to person. In 2015, UK scientists detected MRSA in sausages and minced pork obtained from supermarkets in the UK. They said: “Our findings indicate that this lineage is probably established in UK pig farms and demonstrate a potential pathway for the transmission of LA-MRSA CC398 from livestock to humans in the UK”. Consumers of meat contaminated with MRSA are not thought to be at great risk, but further research is needed to clarify this.
In 2016, very high rates of MRSA ST398 (96 per cent) were found in Portuguese pig farms that used colistin and amoxicillin. Similar levels were seen in Italy where they found MRSA colonisation was significantly higher in intensive farms and in pigs with a recent or ongoing antimicrobial treatment.
More recently, MRSA has been found in abattoir studies in 61 per cent of Spanish pigs, in 60 per cent of German pigs and 39 per cent of Dutch pigs. The emergence of this problem is believed by scientists to be particularly linked to the increased use in farming of modern cephalosporins, which are classified by the WHO as critically important antibiotics (CIAs) in humans.
The number of MRSA-affected pigs in Asia is difficult to quantify, not because of low prevalence but probably due to a shortage of diagnostic facilities. Unlike the widespread of LA-MRSA ST398 in European countries and North America, ST9 predominates in most Asian countries.
According to the Alliance to Save Our Antibiotics: “Most MRSA infections in humans in the UK currently have nothing to do with agriculture, but the recent detection of a small number of cases of MRSA ST398 and other types of MRSA in British cattle is cause for concern. MRSA ST398 has also now been found in British poultry and British pigs”.
They warn that livestock-associated MRSA (LA-MRSA) has caused infections in people in the UK, and experience from other countries suggests that, for MRSA ST398 in particular, there is a real danger that it will spread widely in livestock unless changes in farm antibiotic use are introduced urgently.
Several other types of MRSA are now emerging in pigs in Europe, North and South America, and Asia, and some of these are epidemic human strains that are thought to have transferred initially from humans to animals. If these strains become widespread on farms, says the Alliance, there is a real danger that livestock will become a very important reservoir of human MRSA infections.
LA-MRSA has emerged recently and rapidly; before 2005, MRSA had never been detected in pigs, and the very small number of cases found in other farmed animals were believed to have been incidental transfers from humans.
The pig industry continues to downplay the risk to human health but if MRSA infection levels continue to rise in pigs, it follows that infections in humans will rise too.
A last-line antibiotic called colistin is used when all else has failed. It is an old drug, introduced in 1959, and has been used sparingly in people since then mainly because it can be seriously toxic to the kidneys and nervous system. It is because it hasn’t been used much that bacteria have not developed resistance to it – until now due to the prolific overuse of colistin in farmed animals.
Viva! filmed evidence of colistin use in a pig farm in 2016.
In 2015, E. coli bacteria were discovered in a pig in China that were resistant to colistin. Scientists then tested samples from animals as they were slaughtered, retail meat from supermarkets and street markets, and samples previously taken from patients in two hospitals, collected between 2011 and 2014. The gene they discovered, called mcr-1, which causes resistance to colistin, was present in:
- 78 (15 per cent) of 523 samples of raw pork and chicken meat
- 166 (21 per cent) of 804 pigs in slaughterhouses
- and in 16 (one per cent) of 1,322 samples from hospital patients with infections
Worryingly, the mcr-1 gene was found on a plasmid, these are small pieces of DNA that are not part of a bacteria’s chromosome and are capable of carrying so-called ‘accessory genes’. Plasmids move freely around the bacterial world, hopping from one bacterium to another. This so-called ‘horizontal gene transfer’ rang alarm bells across the scientific community everywhere as it not only heralded the breach of the last group of antibiotics available to humans but opened up the possibility of AMR spreading even faster. Bacteria that carry these mobilised colistin-resistance genes have more recently been referred to as ‘jumping superbugs’!
Following the discovery of mcr-1 in E. coli in China in 2015, UK government scientists re-examined 24,000 archived samples of bacteria from food and humans collected between 2012 and 2015 in the UK and found mcr-1 in 15 samples including Salmonella and E. Coli. The mcr-1 gene was found in E. coli from two pig farms, in stored E. coli from a pig and in three E. coli samples from two human patients, which were also found to be resistant to other antibiotics. It was also found in 10 human Salmonella infections and in Salmonella from a single imported sample of poultry meat. The earliest British positive sample was in a Salmonella isolate from 2012.
In another retrospective study, mrc-1 was found in samples dating back ten years before its discovery in China. Scientists in France screened E. coli isolates for colistin resistance and found 21 per cent were mcr-1-positive. Notably, the oldest had been collected in 2005. Isolates carrying mcr-1 have also been described in Salmonella from clinical samples, food and water in Portugal and in Shigella sonnei from Vietnam.
The mcr-1 gene is spreading fast and has now been found in more than 70 countries across five continents and in numerous species across the world. The mcr-1 gene has been reported among human samples from 29 countries.
In 2016, a second gene for colistin-resistance, mcr-2, was found in E. coli, taken from pigs and cows, prompting scientists to call for an immediate introduction of mcr-2 screening in ongoing surveillance of colistin-resistant pathogens. Then in 2017, a third colistin-resistance gene, mcr-3 was identified in E. coli from pigs in Shandong Province in China and has since been found in Asia, Europe and North America. Many more mcr gene variants have been identified, some retrospectively:
- In 2019, mcr-9 was found in the food poisoning bug Salmonella enterica taken from a patient in Washington State in the US in 2010 (previously tested for resistance to 12 antimicrobials but not colistin). Martin Wiedmann, food safety professor and senior author on the study, warned: “In treatments, if colistin does not work, it literally could mean death for patients. If colistin resistance spreads, a lot of people will die.”
- More recently, yet another colistin-resistant gene, mrc-10, was found in animals, humans and the environment. Scientists say this gene may have been spreading for some time globally under the radar.
Resistance to colistin has happened because of gross overuse of the drug in thousands of millions of animals. It is cheap and used to promote growth and combat disease in filthy, overcrowded factory farms. In 2017, China officially banned the use of colistin as a growth promoter in agriculture, followed by Japan, Malaysia, and Argentina, falling in line with the EU, US, Canada, Brazil, Thailand and more recently, India. However, many countries continue to use it to treat infection. Scientists are unsure if this late action can curb the spread of resistance genes – it could simply be a closing of the barn door after the horse has bolted!
Public Health England said the risk posed to humans by the mcr-1 gene is low but is being monitored closely. The use of colistin to treat infection in animals has been voluntarily restricted by livestock industries in the UK. For the first time ever, no colistin was sold in the UK for use in animals in 2021, but it’s unclear why there hasn’t been a total ban on the use of this last-resort antibiotic. The European Medicines Agency suggests that substances that are of last resort for the treatment of life-threatening diseases in humans should be excluded from veterinary use.
Increasing levels of resistance to colistin are considered to be a major step towards completely untreatable infections, and it remains legal to use colistin in farmed animals in the UK. Many scientists would like to see a complete ban on the use of this last-line antibiotic in farmed animals.
Antibiotics are given to both treat existing disease and to prevent it. Like us, animals are more likely to become ill if they are stressed, overworked or kept in filthy, overcrowded conditions. It is difficult to think of places that fit those criteria more than pig and chicken factory farms across Britain. Viva! has filmed at dozens of pig (and chicken) farms over the past few years and we found suffering, filth and degradation at them all.
It is little wonder that these animals become ill.
Viva!’s report, Pig Farming: The Inside Story (www.viva.org.uk/pigreport) explains why an incredible range of diseases run rife in the UK – including respiratory disease, pleuropneumonia, porcine reproductive and respiratory syndrome (‘Blue ear’), porcine respiratory disease complex (PRDC), pneumonic pasteurellosis, scours (severe diarrhoea), Salmonella, E. coli, lameness, swine dysentery, meningitis, Glässer’s disease, post-weaning multisystemic wasting syndrome (PMWS) and porcine dermatitis and nephropathy syndrome (PDNS).
Further, piglets are weaned far too early, being taken away from their mothers at just three weeks old. This usually leads to digestive problems and diarrhoea (scours) – which are entirely avoidable. Antibiotics are routinely given in pig farms from the moment the piglets are weaned. On a British farm Viva! visited in 2016, investigators found piglets being treated for scours with colistin – an antibiotic that is the last line of defence for human health. Amazingly, the use of colistin on British pig farms is still legal despite scientists finding a gene in pigs, which makes bacteria resistant to it (see above).
Factory-farmed animals are treated with antibiotics to tackle the diseases that are caused by the terrible conditions in which they are imprisoned. In other words, their use and overuse is largely avoidable – by ending factory farming, by not buying the meat. However, antibiotic use is increasing in farmed animals. It is not being reduced or prohibited because factory farming would collapse without it. Due to the increasing global demand for meat, it’s predicted that between 2020 and 2030, antibiotic use in cattle, sheep, chicken and pigs worldwide will increase by eight per cent.
Using antibiotics as growth promoters has been banned in the EU since 2006. However, they are still used in this way in other parts of the world. A report from the World Organisation for Animal Health (OIE) in 2019 found that 45 countries out of 155 that provided data are still giving antibiotics to animals as a way of fattening them up, despite the fact the practice is banned in many parts of the world. Key antimicrobials, classified by the WHO as ‘highest priority critically important antimicrobials’, including colistin, continue to be used routinely in several regions for this purpose.
When used at low levels, some antibiotics have the side effect of promoting growth in animals (and Viva! have filmed these on British farms in 2016). In the UK, there have been some improvements, with antibiotic sales for use in animals falling by 55 per cent between 2014 and 2021. However, it seems likely that some producers are sidestepping the ban on growth promoters (saying that the drugs are being used to prevent disease) and this is driving antibiotic resistance.
Lord Jim O’Neill’s 2016 government-commissioned review on antimicrobial resistance concluded: “In light of this information, we believe that there is sufficient evidence showing that the world needs to start curtailing the quantities of antimicrobials used in agriculture now”.
Perhaps the ultimate irony is the fact that without antibiotics factory farms could not exist, yet once antibiotic resistance is complete the animals on those farms will also not respond to drugs. It will mean the end of factory farming, but by then it would also herald the post-antibiotic age for the human race.
Three-quarters of all antibiotics sold globally are used in animals raised for food. The US and China are the largest users of antibiotics for food production. In the US, around 70 per cent of antimicrobials, which are used to treat human infections are sold for use in food animals.
In 2017, of the 773 tonnes of antibiotics dispensed in the UK, 36 per cent were sold for use in animals (of which less than 10 per cent were used in companion animals and horses) the remaining 64 per cent were for human use. A lower proportion than in many other countries, but still a considerable amount (212 tonnes in 2021).
In the UK, the species with the highest level of antibiotic use is, by far, pigs:
- Pig production data covers >95% of pigs slaughtered in 2021. Total antibiotic usage was 87.3 mg/kg for 2021. Usage reduced by 17.7 mg/kg between 2020 and 2021 and by 69% since 2015.
- Meat poultry (turkeys, broilers and ducks) data covers 90% of the population. Total antibiotic usage was 42.6 mg/kg for turkeys, 13.7 mg/kg for broilers and 1.7 mg/kg for ducks in 2021. This is an increase of 16.8 mg/kg for turkeys, a decrease of 2.6 mg/kg for broilers and a decrease of 0.9 mg/kg for ducks since 2020 and presents a reduction of 81%, 72% and 89% for turkeys, broilers and ducks respectively, since 2014.
- Laying hen data covers 90% of the population. Total antibiotic usage was 0.33 % bird days* in 2021. Usage reduced by 0.14 % bird days since 2020 and by 50% since 2016.
- Gamebird data covers 91% of the population. Total antibiotic usage in gamebirds was 8.9 tonnes in 2021. Usage increased by 3.1 tonnes since 2020 and decreased by 56% since 2016.
- Salmon data covers 100% of the population. Total antibiotic usage was 43.1 mg/kg in 2021. Total antibiotic usage increased by 13.8 mg/kg since 2020 and by 168% since 2017.
- Trout data covers 90% of the population. Total antibiotic usage in was 5.9 mg/kg in 2021. Total usage decreased by 47.9 mg/kg since 2020 and by 69% since 2017.
*A bird-day is the average daily population of birds in the Lion scheme (including breeding birds and pullets in rear) multiplied by 365.
The 2021 data above was collected and provided to the Veterinary Medicines Directorate by the animal industry on a voluntary basis. A disappointing aspect of the figures is that there are no accurate estimates of the current antibiotic consumption by the sheep, dairy and beef sectors, and unlike the other sectors, at the time of writing, plans to centrally collate on-farm antibiotic usage data are still in development. It is, therefore, impossible to get an accurate picture of what is going on without better coverage.

Antibiotics are used in farmed animals for three reasons:
- to promote growth
- to treat disease (therapeutic use)
- to prevent disease (prophylactic use)
It is widely known that pigs are fed antibiotics to make them grow more quickly. Administering low doses of antibiotics in livestock feed improves growth rate, reduces mortality and morbidity, and improves reproductive performance. This has led to the widespread use of antibiotics to promote growth in livestock for many years, thus contributing to the emergence of antibiotic-resistant superbugs.
The use of antibiotics to increase the growth of pigs is well-studied. This use for growth, rather than disease prevention, is referred to as sub-therapeutic antibiotic use. Although it is still not completely understood why and how antibiotics increase the growth rate of pigs, possibilities include metabolic effects, disease control effects and nutritional effects.
An EU-wide ban on the use of antibiotics as growth promoters in animal feed came into effect in 2006, many other countries have also banned their use as growth promoters but the Alliance to Save Our Antibiotics says that in 42 countries, antibiotics are still being used in farmed animals as a way of fattening them up.
To stop the spread of diseases, factory farms often use high levels of antibiotics as a preventative measure rather than a cure. So, many factory-farmed pigs are routinely fed antibiotics, even when they are healthy. Intensive farms make ideal breeding grounds for bugs, so the high stocking density, the stress of factory farming on animals and the low level of genetic diversity all increase the potential for the spread of diseases among animals.
As countries have reduced colistin use in animals, global production has fallen, decreasing, for example, from 13,746 tonnes in 2016 to 4,292 tonnes in 2019. Using colistin to treat infection in animals has been voluntarily restricted by livestock industries in the UK, decreasing by 99 per cent between 2015 and 2017, but it remains unclear why a total ban has not been enforced. In 2019, 1.2 kilograms of colistin was sold for UK animal production and 8.8 kilograms was exported as medicated feed. Poultry and pig industries still account for 96 per cent of total colistin use worldwide, with farms continuing to use it as a preventive measure and for individual treatment of livestock.
The large amount of antibiotics used in factory farming is a significant cause of the resistance of many common bacteria to the antibiotics relied on to treat infections in humans.
Over the last few decades, a huge increase in meat production has occurred in developing countries – especially for poultry and pork. China alone produces and consumes roughly half the planet’s pigs – about 500 million annually and it is estimated that half of the antibiotics used in China are given to farmed animals.
The increase in meat consumption in developing countries is following what happened in developed countries over the last 100 years as incomes rose; factory farming leading to the overcrowding of animals and the use of huge volumes of antibiotics. In many developing countries, the use of antibiotics continues; for growth promotion, disease prevention and therapeutic purposes. While some countries (the UK for example) have reduced the amount of antibiotics used in livestock, between 2020 and 2030, global consumption of antimicrobials is predicted to increase by eight per cent. Higher global use in 2030 will likely be associated with increasing use in Asia, Oceania and the Americas.
Additionally, water is frequently contaminated with large numbers of resistant bacteria and their resistance genes – both by faecal contamination from people (poor sanitation) and animal manure. This contaminated water then recirculates to people and food animals given antibiotics, which then allows even more resistance to develop and spread. In India, for example, a large proportion of community-based urinary tract infections (UTIs), caused by resistant E.coli, are essentially untreatable. In many waterways in India (and elsewhere) resistant bacteria are frequently present and AMR trends in UTI patients indicate that it is imperative to rationalise the use of antimicrobials and to use them conservatively.
The large volumes of antibiotics used in livestock in developing countries are contributing to the problem of AMR. Unfortunately, AMR does not recognise geographic borders – we all share one planet. The most effective way to tackle AMR and achieve optimal health for people, animals and our environment is to change the way we live and eat, reducing antibiotic use in humans and animals.
Overall, limiting the routine use of antibiotics used in animal feed will improve human and animal health, by reducing the development and spread of antibiotic-resistant bacteria. Therefore, the judicious use of antibiotics in agriculture as well as healthcare settings is essential to slow the emergence of AMR and preserve the effectiveness of the antibiotics that we have today.
In July 2014, then-Prime Minister David Cameron was sufficiently concerned about antibiotic resistance that he commissioned a review by economist Jim O’Neill to analyse the problem. Cameron said: “If we fail to act, we are looking at an almost unthinkable scenario where antibiotics no longer work and we are cast back into the dark ages of medicine.”
The review concluded that antibiotic use in farmed animals should be cut, but the suggested reduction did not go far enough. David Cameron also suggested a ban on farm use of antibiotics which are classified as critical for human health. This has yet to happen and may now not, as Cameron’s influence dwindled when he stepped down. Many of his fellow politicians – including those running the Governments’s agricultural departments – remain sceptical and fearful of angering farmers.
The UK has cut the amount of antibiotics used in farmed animals, but the number of drug-resistant bloodstream infections increased, by 35 per cent from 2013 to 2017, and the latest data published by the UK Health Security Agency (UKHSA) reveals that the estimated total number of serious antibiotic-resistant infections in England rose by 2.2 per cent in 2021 compared to 2020 (53,985 compared to 52,842). This is the equivalent of 148 severe antibiotic-resistant infections a day in 2021.
This suggests either the action has been too little too late, or that the amount used before the reduction was hugely excessive.
In 2019, the government published a 20-year vision and five-year national action plan for how the UK will contribute to containing and controlling AMR by 2040. Targets included:
- cutting the number of drug-resistant infections by 10 per cent (5,000 infections) by 2025
- reducing the use of antibiotics in humans by 15 per cent by 2024
- preventing at least 15,000 patients from contracting infections as a result of their healthcare each year by 2024
- reducing UK antibiotic use in food-producing animals by 25 per cent between 2016 and 2020 and define new objectives by 2021 for 2025
The report said: “As in humans, the sub-optimal use of antimicrobials in agriculture and veterinary practice contributes to the rise and spread of AMR all over the world”.
In 2019, then-Health and Social Care Secretary Matt Hancock said: “Each and every one of us benefits from antibiotics, but we all too easily take them for granted, and I shudder at the thought of a world in which their power is diminished. Antimicrobial resistance is as big a danger to humanity as climate change or warfare. That’s why we need an urgent global response.”
We are still waiting for the urgent global response…
No new classes of antibiotics have been discovered since the 1980s. A class refers to a group of antibiotics that have a certain way of working – for example by killing bacteria or by stopping them from multiplying – and are effective against certain types of infections. The antibiotics that have been developed in the past three decades are variations of ones that have been discovered before. Only eight new antibacterial agents have been approved since 2017, and they offer little improvement on existing drugs.
Developing a new antibiotic is challenging and can take 10-15 years and cost over $1billion. According to Antibiotic Research UK: “It can cost billions of pounds and take many years to produce a new antibiotic, and resistance to new treatments can arise very quickly. This means many pharmaceutical companies would rather focus on developing other treatments, which have better profit margins”.
Pharmaceutical companies recoup the money used to develop new drugs through the sales of those drugs. While this works well for medicines used to treat cancer, diabetes, chronic pain and asthma, it is not so effective when it comes to antibiotics as they need to be used sparingly and not sold in large volumes. So, the incentives are not sufficient to stimulate new investment in antibiotic research and development.
‘Big pharma’ is not investing in new antibiotics and there are worryingly few new drugs in development to deal with the worsening crisis of AMR. The World Health Organisation says that efforts to discover new antibiotics are “insufficient to tackle the challenge of increasing emergence and spread of antimicrobial resistance”. The limited research that is being undertaken is generally by small or medium-sized companies, “with large pharmaceutical companies continuing to exit the field”.
When an antibiotic is used frequently, it is not long before bacteria become resistant to it. If new antibiotics were reserved only for use in treating resistant infections, then most of the time they would sit on the pharmacy shelf not required until a patient presents with an antibiotic-resistant infection. Again this disincentivises any commercial company to develop new antibiotics.
Money. Any cut in their usage will cut their profits accordingly. In fact, the industry actively campaigns to keep antibiotics being used in the farming industry – and promote even more being produced and dished out.
A joint investigation by the Guardian and the Bureau of Investigative Journalism found that Elanco (who account for 13 per cent of the veterinary pharmaceuticals and operates in more than 70 countries) is using slick advertising campaigns on social media to downplay consumer concerns over giving antibiotics to animals.
In the UK, the Responsible Use of Medicines in Agriculture Alliance (RUMA), an alliance representing the interests of the pharmaceutical and intensive-farming industries which is opposing attempts to ban the routine preventative use of antibiotics in farming, has dismissed the claim that the overuse of antibiotics in intensive farming adds to the serious public-health threat from antibiotic resistance as a ‘myth’, despite the wealth of evidence to the contrary.
The Alliance to Save Our Antibiotics states: “…although government scientists have produced many high-quality studies over the past decades examining the farm resistance issue, government officials recognise that implementing significant restrictions on antibiotic use in farming could increase costs. A report published in 2012 by Defra and Department of Health scientific advisors and officials argued against taking too many measures at an EU level, saying this could put EU farmers at a commercial disadvantage leading to more imports.
The report warned that costs might increase because fewer animals might survive and because “livestock have to be kept more extensively or in better buildings to minimise risks of becoming infected, such as avoiding pneumonia by building better designed, well-ventilated buildings”. They said: “The implementation of UK (or EU)-only antimicrobial resistance control measures could put the economic viability of those keeping livestock at a disadvantage”.
The report concluded that “Unless consumers are prepared to pay a premium for food produced by means designed to lower the risk of transmitting antimicrobial resistance (while not compromising animal welfare) the potential for unintended consequences of certain measures that may be used to control antimicrobial resistance is high”.
As a result, despite accepting that improving the conditions in which animals are reared can result in significant improvements in antibiotic use, Defra officials largely continue to support the status quo.
Like doctors being encouraged to prescribe fewer antibiotics to people vets have also been encouraged to prescribe fewer antibiotics to farmed animals. Some surely are. However, those working within farmed animal practices rely on the custom of farmers and if they refuse to give out antibiotics those farmers could go elsewhere. Vets are aware that factory farming practices drive illness and disease and so increase antibiotic usage yet continue to prescribe drugs to treat avoidable disease and illness. It is also unclear how many vets have ties to pharmaceutical companies.
Free range, organic or higher-welfare indoor farming, may use lower levels of antibiotic use but it is a myth that organic farming is automatically antibiotic-free. Antibiotics will be given to animals in organic farming on the advice of vets. Meat from organic animals cannot be sold if the animal is receiving antibiotics or for a period afterwards, but organic farming still plays its part in driving antibiotic resistance.
Whilst welfare on less intensive systems can be better (although not always) there are other issues to consider. Extensive farming takes up a lot more room and there simply isn’t enough space in Britain to farm all the animals we currently do in less intensive systems. Organic animals tend to be slaughtered at a later age than intensively farmed ones, so often more feed will need to be produced for organic herds. And, of course, all animals – whether organic or factory farmed – end up at the abattoir for something that we don’t even need and that harms our health.
Unfortunately, being vegan will not stop you falling victim to an untreatable infection if antibiotics stop working. However, going and being vegan means that you are healthier and less likely to get ill. For example, 95 per cent of food poisoning cases are caused by consuming animal products. Also, as the risk of antibiotic resistance increases each time an antibiotic is used, as a vegan, it means that no animals will be raised for meat, fish, dairy or eggs in your name and so fewer antibiotics are used. The more of us who reject factory farming and choose a kinder future will help protect us all. You can forget governments, supermarkets, vets and farmers being key to the solution. Being vegan is the best chance we have to collectively prevent reaching the point of no return. In fact, it may be our only chance.
As an EU Member State, the UK adopted the EU-wide ban on the use of antimicrobials as growth promoters that came into force on 1 January 2006. The addition of antimicrobials to animal feed for medical purposes (either as prophylactics or as treatment for existing disease) was not affected by this ban. Since the UK left the EU, the EU has extended the scope of its ban.
In January 2022, the routine use of antibiotics was banned and preventative use was restricted to exceptional treatments of individual animals.
Antimicrobials can also no longer be applied to compensate for poor hygiene and animal husbandry practices. An EU summary of the regulation states that the new rules continue and strengthen the EU’s fight against antimicrobial resistance by introducing:
• a ban on the preventive use of antibiotics in groups of animals;
• a ban on the preventive use of antimicrobials via medicated feed;
• restrictions on the use of antimicrobials as a control treatment to prevent a further spread of infection;
• a reinforced ban on the use of antimicrobials for promoting growth and increasing yield (in addition to the 2006 prohibition of using antibiotics as growth promoters in feed);
• the possibility to reserve certain antimicrobials for use in humans only;
• the obligation for EU Member States to collect data on the sale and use of antimicrobials;
• various measures aiming towards the careful and responsible use of antimicrobials.
For exports into the EU, non-EU countries will have to “respect the ban on using antimicrobials for promoting growth and increasing yield and the restrictions on antimicrobials designated as reserved for human use in the EU”.
Will the UK follow the 2022 EU ban?
Commentators are concerned that the UK will fall behind EU efforts without a similar ban. The Government’s 5- year action plan for antimicrobial resistance published in 2019 said that the UK would align with new EU regulations on veterinary medicines. However, an addendum to the plan published in May 2022 replaces this with a commitment with to “implement similar provisions” to the EU regulations.
Farming Minister Mark Spencer set out Defra’s approach in a PQ on Livestock: Antibiotics answered on 9 January 2023, and said that the Government does not support the routine or predictable use of antibiotics, “including where antibiotics are used to compensate for inadequate farming practices”. He said that its approaches to reducing this type of use included “improved biosecurity, stockmanship and good farming practices; disease prevention (including vaccination); and use of diagnostics”. Mr Spencer said that the Government proposed to strengthen national law on unnecessary antibiotic prescribing in animals.
The UK Veterinary Medicines Directorate had been in dialogue with stakeholders in 2022 about changes to the Veterinary Medicines Regulations 2013 which set out controls on marketing, manufacturing, supply and use of veterinary medicines. A full consultation was being prepared, with legislation expected to be laid in 2023.
This content was written by Juliet Gellatley, and reviewed by Dr Justine Butler.